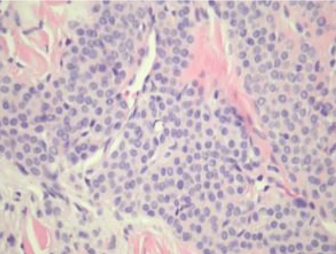

Presenter: Francisca Valenzuela, MD, Thomas L Davis, MD, Michael Hohnadel, DO
Dermatology Program: South Texas Dermatology Residency, HCA Healthcare Corpus Christi Medical Center – Bay Area Program
Program Director: Rick Lin, DO MPH FAOCD
Submitted on: March 22, 2023
CHIEF COMPLAINT: Painful nodule on finger nail
CLINICAL HISTORY: A 79-year-old female with no significant past medical history presented to the clinic with a painful nodule on her left third fingernail that had been present for 10 years. The patient reported that the nodule had been slowly growing and became very painful when she submerged her hand in cold water. For the past two years, she had been treated by a midlevel provider who diagnosed her with onychomycosis and a bacterial infection of the left third fingernail. Despite multiple courses of doxycycline and ciclopirox, she noted no improvement in her condition.
PHYSICAL EXAM:
On physical examination, the patient has a solitary, painful, 1-2 cm reddish-blue nodule on the center of the left third fingernail.
LABORATORY TESTS: N/A
DERMATOHISTOPATHOLOGY:
Histopathologic studies revealed endothelium-lined spaces surrounded by monomorphous cells with pink and pale cytoplasm and round nuclei within the dermis.
DIFFERENTIAL DIAGNOSIS:
-
- Angiolipoma
- Neuroma
- Granular Cell Tumor
- Glomus Tumor
- Endometrioma
- Leiomyoma
- Subungual Hematoma
- Melanoma
- Squamous Cell Carcinoma
- Foreign Body